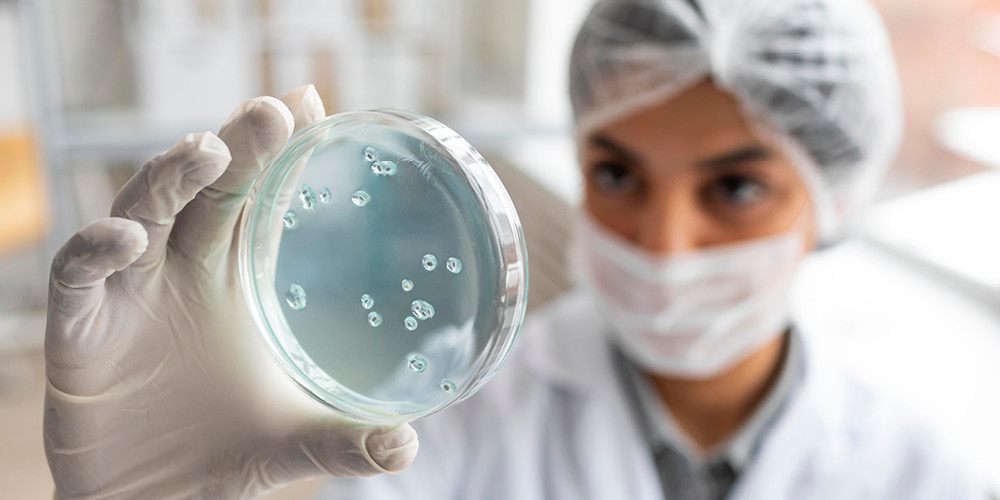
Understanding Egg Quality and Its Impact on IVF Success

Quality egg health is not just the number of eggs. Their health and genetic stability are also points to consider. Generally, younger women have better quality eggs; however, increased age comes with a rise in the chances of chromosomal abnormalities. This, however, does not mean that older women won't conceive, but it stresses the need for early testing and treatment.
At Dr. Aravind's IVF, which is also known as the Best IVF Centre in Bangalore, efforts are made to assist women on how their egg health affects treatment. Couples can look to receive the guidance and advanced testing required along with individualized care that really clarifies their parenthood planning journey.
The most important of lifestyle changes. A balanced diet comprising vitamins and antioxidants, regular physical activity, ideal body weight, and reduced stress can support reproduction to a large extent. Avoiding environmental toxins makes a difference too. At Dr. Aravind's IVF, women are realistic approaches that boost their fertility potential. The changes made not only facilitate egg health but also enhance the overall well-being, preparing the body for pregnancy.
Checking egg quality is important before starting any fertility treatment. It is from a Female Egg Quality Test that one can ascertain his or her ovarian reserve and whether the eggs produced would be capable of giving rise to a healthy pregnancy. Knowing your egg quality gives couples a sense of clarity. Instead of pursuing treatment blindly, they have clearer photographs of what is to come. For most of women, this is the initial step in organizing their fertility journey. Whether fertility is high or low, knowledge enables medical professionals to suggest more specialized therapies to get desired effects.
The Anti Mullerian Hormone (AMH) is, alongside a few other markers, the best marker to assess ovarian reserve. AMH level, measured in a simple blood test, indicates how many eggs are left in the ovaries. Higher levels indicate better ovarian reserve, lower levels suggest infertility. At Dr. Aravind's IVF, AMH testing is standard on women who are starting fertility treatment. The main advantage is that it gives doctors and patients some baseline understanding. This would help the doctors identify whether one should start treatment immediately or could afford to wait. This will also help in personalizing the medications for ovarian stimulation, thus making the whole treatment smoother and tailor-made.
It's the pressure of the unknown that evokes anxiety in many couples with regard to the IVF Treatment Process. In this regard, Dr. Aravind's IVF clarifies every detail of the IVF procedure, which has the aim of relieving anxiety and growing confidence. It starts with controlled ovarian stimulation: a hormonal treatment whereby the ovaries are induced to produce multiple eggs. After maturation, the eggs are retrieved in a simple procedure. They are then fertilized in the lab using either IVF or advanced techniques like ICSI-as indicated by the case.
The embryos develop under close monitoring and grading. Transfer to the uterus will be made only of the healthiest embryos. This is the time when egg quality truly matters; good quality eggs will result in embryos that are generally of better quality and have higher implantation potential. Therefore, we focus on assessing egg quality early and improving egg health before treatment.
Searching for an IVF Center Near Me can often be overwhelming; after all, many clinics may promise results without actually giving guidance. What makes Dr. Aravind's IVF truly special is its blend of technology and compassion. A patient is never treated as just another case number. Each couple has an individualized care plan designed to attend to their peculiar needs.
To couples, it simply matters to have advanced fertility clinics nearby. When the location of the clinic is such that scans, blood tests, and procedures are frequent, visits become hassle-free. But beyond the location is the factor of trust. This is where Dr. Aravind's IVF shines in today's world; not just for the geographical space, but also because of the atmosphere wherein each patient feels listened to and cared for.
Couples searching for the Top IVF Center in India want reassurance that they are receiving world-class care. At Dr. Aravind’s IVF, international standards of fertility treatment are combined with personalized Indian care. The reputation of the clinic is not so much because of its advanced technology, but it also stems from the attitude which takes care of medical and emotional needs. Patients can take comfort in the fact that they are getting treatment at one of the best centers in the country. Maximum levels of safety and success are ensured at every treatment point through established protocols, from diagnosis to embryo transfer. If you are searching for Best IVF Center Near Me The kind of trust Dr. Aravind's IVF has earned in the country rests on a fine integration of expertise, technology, and the personal touch.
The search by couples for the Best Fertility Centre in Bangalore in Karnataka quite often leads them toward Dr. Aravind's IVF. Over the years, our Centre has earned an ever-growing reputation for its successes and satisfied clients. It is a trusted option for infertile couples, with advances in laboratory technology, an excellent team of embryologists, and above all, transparency in communication.
Behind every successful procedure lies expertise. Having the Best IVF Specialist in Bangalore by your side means much more than just technical expertise; it is also someone walking alongside you in your journey. Dr. Aravind Chander Known for the name of Best IVF Specialist in Bangalore has many years of experience precisely and sensitively handling the most challenging fertility cases. Contact us at +91 90 2012 2012 to book your appointment and find out about our IVF Cost.
Normal egg quality means having the right chromosomes and being matured enough to allow fertilization, embryos' development, and implantation into a healthy pregnancy. Possessing abundant nutrients, excellent DNA, and beautiful architecture to carry on with early development are qualities attached together with good-quality eggs. Simple words specify eggs of good quality for normal maturation, fertilization, cellular division (cleavage), and so on without errors.
Egg quality cannot be directly seen, but there are signs and symptoms that a doctor looks for. Testosterone production is low, but the ovarian reserve is tested by conducting tests of AMH and counting antral follicles. Good embryos in an IVF setting can be clinically defined as those that fertilize with ease, have optimal morphology, and reach the blastocyst stage of development in vitro. Other reassuring signs - consistent ovulation and regular cycles - are indeed comforting to the woman.
Around the age of 20, and particularly between 20 and 30, the egg quality reaches its peak. After 30 years, there is a gradual reduction in egg quality which becomes marked after the age of 35. By the beginning of the 40s, the quantity of normal eggs left is minimal, and the chances of chromosomal aberrations are maximized. For these reasons, doctors usually stress age as the culprit for the majority of issues related to fertility.
Yes, stress tends to exert indirect influence over egg quality. An increase in stress hormones may disturb hormonal equilibrium and ovulation while restraining blood supply to the ovaries. An additional side effect of prolonged stress would be to increase production of cortisol, known to affect the reproductive system. This puts stress notwithstanding, will not have effects on egg quality; however, chronic stress creates a barrier to conception as well as reproductive health.
The research finds that omega-3 fatty acids might improve egg quality. Omega-3s provide blood flow to the ovaries, reduce inflammatory reactions, and assist in the orchestration of hormone balancing signals. In addition, omega-3s maintain membrane integrity, thus important for egg health. In simplified terms, omega-3s may not be the most magical of all supplements, but they definitely assist in helping maintain healthy eggs when taken from sources that include salmon, flaxseeds, which means walnuts, and incorporated into a woman's diet.